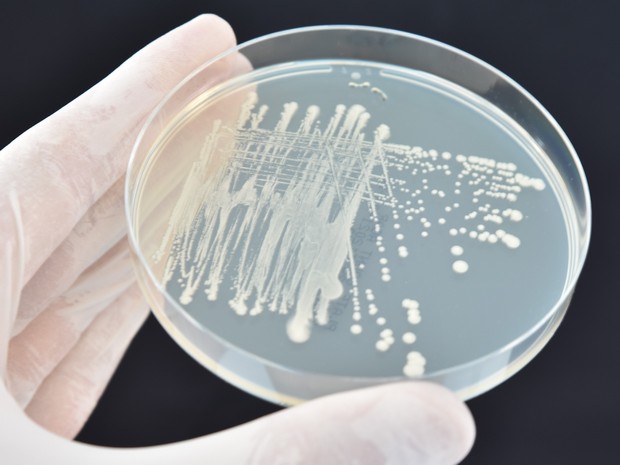

Das menschliche Hautmikrobiom
Das menschliche Hautmikrobiom ist ein komplexer Kosmos auf unserer Hautoberfläche und beschreibt das Zusammenspiel der dort angesiedelten Mikroorganismen. Zu unserer Hautflora zählen Milliarden Organismen wie Bakterien, Pilze, Viren und Einzeller. Eine gesunde Haut besitzt ein ausbalanciertes Mikrobiom und ist Bestandteil des menschlichen Immunsystems. Es schützt dabei die Haut vor fremden Mikroorganismen durch Absenkung des pH-Wertes für den natürlichen Säureschutzmantel, produziert antimikrobielle Peptide, welche das Wachstum von Krankheitserregern hemmen und ist an Regenerationsprozessen der Haut beteiligt.
Das Mikrobiom eines Menschen ist dabei so unterschiedlich, wie ein Fingerabdruck, denn die lebenden Mikroorganismen unterscheiden sich von Körper zu Körper und variieren je nach Alter, Geschlecht, Hygieneverhalten, Lebensstil und unserer Umwelt. Aber selbst unterschiedliche Hautareale besitzen ein einzigartig zusammengesetztes, lokales Mikrobiom.


Dysbiose des Mikrobioms und Erkrankungen der Haut
Das natürliche Gleichgewicht des Hautmikrobioms verhindert die Ansiedelung von pathogenen Erregern auf unserer Haut. Bei Störung des gesunden Mikrobioms, können sich Hauterkrankungen bis hin zu systemischen Erkrankungen entwickeln.
Obwohl der Ausbildung solcher Erkrankungen, wie beispielsweise Atopischer Dermatitis, Psoriasis, Neurodermitis oder Akne, oft ein komplexes Zusammenspiel vieler Einflussfaktoren zugrunde liegt, ist ein dereguliertes, dysbiotisches Mikrobiom sehr häufig mit diesen Erkrankungen assoziiert.
Der Mikrobiomtest zur Verträglichkeitsprüfung von Kosmetikprodukten
Die Haut und unser Mikrobiom ist ständig inneren und äußeren Einflüssen ausgesetzt, welches auf das Gleichgewicht des Hautmikrobioms Einfluss nehmen können. Neben inneren Faktoren wie Alter, Geschlecht oder genetischer Veranlagung können auch äußere Faktoren wie Wetter, UV-Strahlen, Kleidung oder Verwendung von Kosmetikprodukten das Hautmikrobiom beeinträchtigen.
Daher rückt die Verträglichkeit von Kosmetikprodukten mit unserem Hautmikrobiom immer stärker in den Fokus.
Genau hier setzt unser Mikrobiom-Verträglichkeitstest an…

Was wird im Mikrobiom-Verträglichkeitstest untersucht?
Der Hautmikrobiom-Test wird zur Untersuchung von Kosmetika, Pflegeprodukten bzw. deren Inhaltsstoffe herangezogen, die direkt mit der menschlichen Haut in Kontakt kommen. Das Verfahren untersucht dabei den Einfluss des Produktes auf die Organismen des sog. Kern-Hautmikrobioms. Ein intaktes Hautmikrobiom besitzt eine fundamentale Schutzfunktion für die menschliche Haut. Produkte mit Hautkontakt sollten daher eine gute Verträglichkeit mit der Balance und Schutzfunktion unseres Hautmikrobioms aufweisen. Der Test ist ein in-vitro Verfahren, wodurch ein hohes Maß an Reproduzierbarkeit der Testergebnisse erzielt werden kann.
Untersuchungsaspekte des Mikrobiom-Verträglichkeitstests
Aufrechterhaltung der Vitalität der Mikroorganismen des Kern-Mikrobioms
Bei diesem Testaspekt wird das Wachstumsverhalten der einzelnen Leitorganismen des Hautmikrobioms im Vergleich zu einem unbehandelten Kontrollansatz untersucht.
Aufrechterhaltung der Diversität des Mikroorganismen
Bei diesem Testaspekt wird der Einfluss des Kosmetikprodukts auf die Veränderung der Zusammensetzung der ausgewählten Mikrobiom-Leitorganismen in Gegenwart des Testproduktes im Vergleich zur einem unbehandelten Kontrollansatz untersucht.
Aufrechterhaltung der Hautschutzfunktion
Die mikrobiellen Schutzfunktion ist eine essentielle Aufgabe des Hautmikrobioms. Hierzu werden die Leitorganismen in eine 3D Matrix eingebettet. Nach Etablierung des Systems (Einstellung des sauren pH-Wertes und Produktion antibakterieller Peptide, sog. Bacteriocine) wird nach Auftrag des Testproduktes die Ansiedelung von Staphylococcus aureus als pathogener Teststamm auf der Oberfläche untersucht.
Flexibilität des Mikrobiom-Verträglichkeitstests
– Teststandards für Mikrobiome unterschiedlicher Hautareale
– Individuelle Anpassung des Mikrobioms je nach Applikation möglich
– Anpassung an dysbiotische Hautmikrobiome
– Spezielle Verfahren für Leave-On und Rinse-Off-Produkte
– Funktioneller Bacteriocin-Nachweis
– UV A / UV B Strahlungstest auf das Mikrobiom
– Surface Protection Test: Wirksamkeitsnachweis von antimikrobiell aktiven Produkten
– Untersuchung der zeitlichen Wirkkinetik von antimikrobiellen Produkten
Was bringt mir der Hautmikrobiom-Verträglichkeitstest?
Der Hautmikrobiom-Verträglichkeitstest liefert wissenschaftlich fundierte Testergebnisse zur Verträglichkeit des Testproduktes auf die Leitorganismen des menschlichen Kern-Hautmikrobioms. Die Untersuchungen werden an Lebendorganismen durchgeführt, so dass Einflüsse auf den Metabolismus der Mikroorgansimen physiologisch mitberücksichtigt werden.
Die verwendeten in-vitro Methoden zeichnen sich durch ein extrem hohes Maß an Reproduzierbarkeit und Schnelligkeit aus.
Der bestandene Hautmikrobiom-Verträglichkeitstest bestätigt, dass das Prüfprodukt das natürlich Mikrobiom der Haut und seine Schutzfunktion unterstützt.
Mit unserem Mikrobiom-Verträglichkeitstest unterstützen wir Aussagen wie:
freundlich zum Mikrobiom, schonend zum Mikrobiom, verträglich zum Mikrobiom, bewahrt die Diversität des Mikrobioms, …














